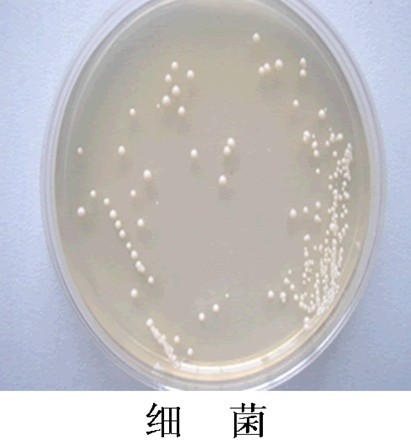
細(xì)菌
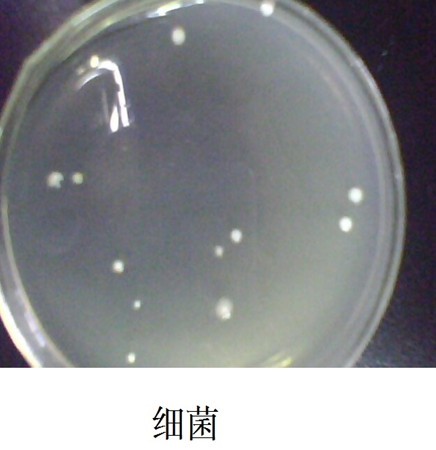
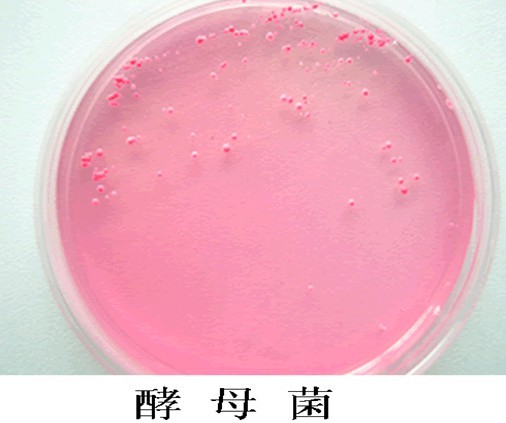

•微生物 :
一般地,將微生物劃分為以下8大類細(xì)菌、病毒、真菌、放線菌、立克次體、支原體、衣原體、螺旋體

1. 高壓蒸汽滅菌鍋的用途
2. 高壓蒸汽滅菌鍋工作原理
3.高壓蒸汽滅菌鍋的結(jié)構(gòu)
4. 使用與操作方法
5. 維護(hù)與保養(yǎng)
6.故障分析與排除
高壓蒸汽滅菌鍋用途廣,適用于醫(yī)療衛(wèi)生事業(yè)、科研、農(nóng)業(yè)等單位;對(duì)醫(yī)療器械、敷料、玻璃器皿、溶液培養(yǎng)基等進(jìn)行消毒滅菌,也適用于高原地區(qū)作蒸餐設(shè)備和企事業(yè)單位制取高質(zhì)量飲用水,也可作為制取高溫蒸汽源設(shè)備,是微生物學(xué)實(shí)驗(yàn)中**常用的滅菌方法。
這種滅菌方法是基于水的沸點(diǎn)隨著蒸汽壓力的升高而升高的原理設(shè)計(jì)的。

高壓蒸汽滅菌的原理:基于水在煮沸時(shí)所形成的蒸汽不能擴(kuò)散到外面去,而聚集在密封的容器中,在密閉的情況下,隨著水的煮沸,蒸汽壓力升高,溫度也相應(yīng)增高。
壓力:100KPa,水蒸氣的溫度:115℃,時(shí)間:20min,可殺死各種微生物和它們的孢子
壓力:147KPa,水蒸氣的溫度:121℃,時(shí)間:15~30min ,各種微生物和它們的孢子或芽孢
壓力:156KPa,水蒸氣的溫度:180℃,時(shí)間:4h,熱原質(zhì)(Pyrogen):熱原質(zhì)即菌體中的脂多糖
壓力:156KPa,水蒸氣的溫度:250℃,時(shí)間:45',熱原質(zhì)(Pyrogen):熱原質(zhì)即菌體中的脂多糖
壓力:156KPa,水蒸氣的溫度:650℃,時(shí)間:1',熱原質(zhì)(Pyrogen):熱原質(zhì)即菌體中的脂多糖
溫度越高,需時(shí)越短,熱穿透能力越強(qiáng)。一般認(rèn)定115℃-121.3℃,對(duì)培養(yǎng)基的成分不產(chǎn)生破壞。

控制面板上的溫度壓力表









3.加水
將純水直接注入鍋內(nèi)約8升,觀察控制面板上的高水位燈,亮?xí)r方可停止加水,當(dāng)水過(guò)多應(yīng)開啟下排水閥放去多余水
4.放需滅菌的物品
把裝有生理鹽水的三角瓶放在滅菌筐內(nèi),應(yīng)留有一定間隙,這樣有利于蒸汽穿透,提高滅菌效果
5.蓋上鍋蓋
將手輪向左旋轉(zhuǎn)數(shù)圈,使鍋蓋向下壓緊鍋體,以確保密封開關(guān)處處于接通狀態(tài)。當(dāng)連鎖燈亮?xí)r,顯示容器密封到位

6.設(shè)定溫度和時(shí)間
按一下確認(rèn)鍵,按動(dòng)增加鍵,將溫度設(shè)定在121度,再按動(dòng)一下確認(rèn)鍵,按動(dòng)增加鍵,設(shè)定時(shí)間為20分鐘,**后再按確認(rèn)鍵,溫度和時(shí)間設(shè)定完畢

7. 滅菌
第六步結(jié)束后,進(jìn)入自動(dòng)滅菌程序,當(dāng)鍋內(nèi)壓力達(dá)到約0.03MPa時(shí),欠壓蜂鳴器停止蜂鳴,壓力燈亮,隨溫度升溫,當(dāng)滅菌室內(nèi)到達(dá)所設(shè)定溫度,加熱燈滅,自動(dòng)控制系統(tǒng)開始進(jìn)行滅菌倒計(jì)時(shí),并在控制面板上的設(shè)定窗內(nèi)正在顯示所需滅菌時(shí)間
8.滅菌結(jié)束
關(guān)電源,將排汽排水閥向左旋轉(zhuǎn),排除蒸汽,當(dāng)壓力表上壓力指示針指到0時(shí),方可啟蓋取出滅菌物品

1.推放滅菌物品時(shí),嚴(yán)禁堵塞安全閥和放氣閥,必須留出空位保證其空氣暢通,否則易造成容器爆裂
2.滅菌液體時(shí),盛液不超過(guò)容器的3/4
3.針對(duì)不同滅菌指標(biāo)的物品,不能一起滅菌
4.滅菌終了時(shí),若壓力表指示針已經(jīng)回復(fù)零位,而鍋蓋不易開啟時(shí),可將放氣閥摘子置于放氣位置,使外界空氣進(jìn)入鍋內(nèi),真空消除后,方可開蓋
5. 壓力表使用日久后,壓力指示燈不正確或不能回復(fù)零位,應(yīng)及時(shí)予以檢修
6. 經(jīng)常保持設(shè)備的清潔與干燥,可以延長(zhǎng)其使用壽命,橡膠密封圈使用日久會(huì)老化,應(yīng)定期更換
7.應(yīng)定期檢查安全閥的可靠性,工作壓力超過(guò)0.165MPa時(shí)不起跳,需更換合格安全閥
|
故障現(xiàn)象 |
原因分析 |
排除方法 |
|
壓力表溫度與數(shù)字顯示不一致 |
鍋內(nèi)存有冷空氣 |
適量開啟排汽排水閥 |
|
水位超過(guò)高水位,高水位燈不亮 |
水位器內(nèi)孔堵塞異物 |
疏通管道 |
|
高水位燈亮,顯示溫度不上升 |
a.保溫時(shí)間未設(shè)定b.固態(tài)繼電器損壞c.電熱管損壞 |
a.設(shè)定保溫時(shí)間b.更換固態(tài)繼發(fā)器c.更換電熱管 |
|
工作狀態(tài),外殼帶電 |
a.電熱管損壞.b電源無(wú)接地線 |
a.更換電熱管,b安裝接地線
|
|
紅色數(shù)顯窗為------- |
溫度傳感器損壞,電腦板損壞 |
更換溫度傳感器,更換電腦板 |
|
數(shù)顯窗為 0 0 0 0 |
電腦板損壞 |
更換電腦板 |
|
鍋內(nèi)無(wú)水,加熱燈亮 |
水位端接觸銅殼 |
迅速切斷電源 |
|
壓力表內(nèi)有水蒸氣 |
接頭漏氣 |
擰緊接頭 |